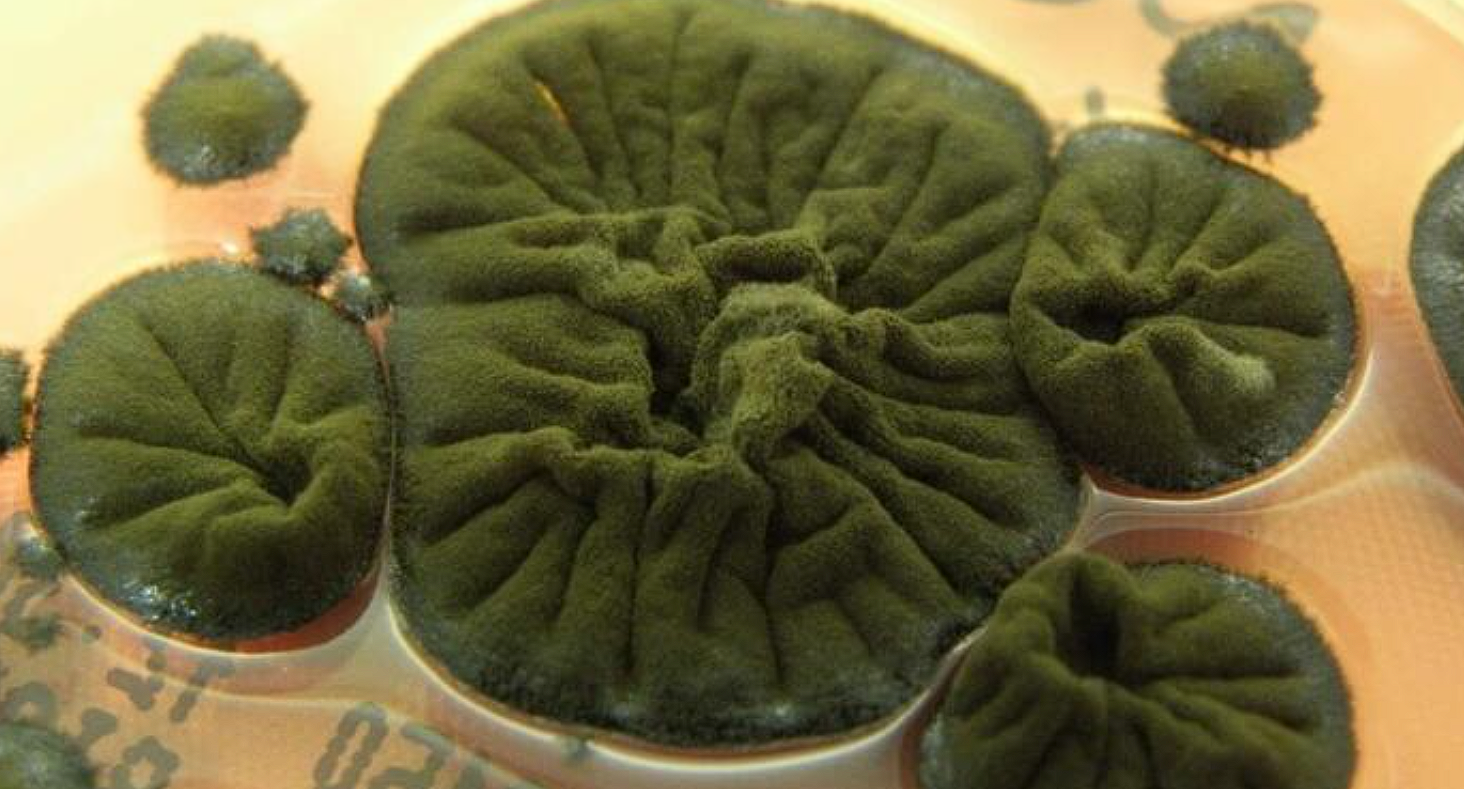
Ð§ÐµÑÐ½ÑÐ¹ Ð³ÑÐ¸Ð±Ð¾Ðº Cladosporium sphaerospermum. Ð¤Ð¾ÑÐ¾ - atlasmicologia.blogspot.com

Исследователи обнаружили, что C. sphaerospermum, как и многие другие организмы, найденные в саркофаге реактора, имеет очень темный цвет. Ученые предполагают, что этот темный пигмент — меланин — действует аналогично хлорофиллу у растений, но вместо света преобразует ионизирующее излучение в химическую энергию для роста.
Ионизирующее излучение опасно для большинства форм жизни, поскольку оно разрушает молекулы и повреждает ДНК. Однако эксперименты, проведенные после первого открытия грибка в конце 1990-х годов, показали, что радиация не только не вредит C. sphaerospermum, но даже стимулирует его рост.
Уникальные свойства грибка вызвали интерес не только биологов, но и инженеров. В 2022 году C. sphaerospermum был доставлен на борт Международной космической станции (МКС), где подвергся воздействию космической радиации.
Исследование подтвердило, что грибок обладает способностью экранировать излучение. Это открывает перспективы для использования меланинсодержащих грибов в качестве биологического щита для защиты астронавтов и оборудования во время длительных космических миссий.
Тайна остается неразгаданной
Несмотря на все данные, механизм радиосинтеза до сих пор остается гипотетическим и до конца не доказан. Ученым пока не удалось продемонстрировать точное метаболическое преобразование или процесс фиксации углерода, зависящий от радиации.
Тем не менее, сам факт, что жизнь смогла не только адаптироваться, но и найти способ процветать в смертельно опасной зоне, остается одним из самых удивительных открытий, сделанных в Чернобыльской зоне отчуждения.